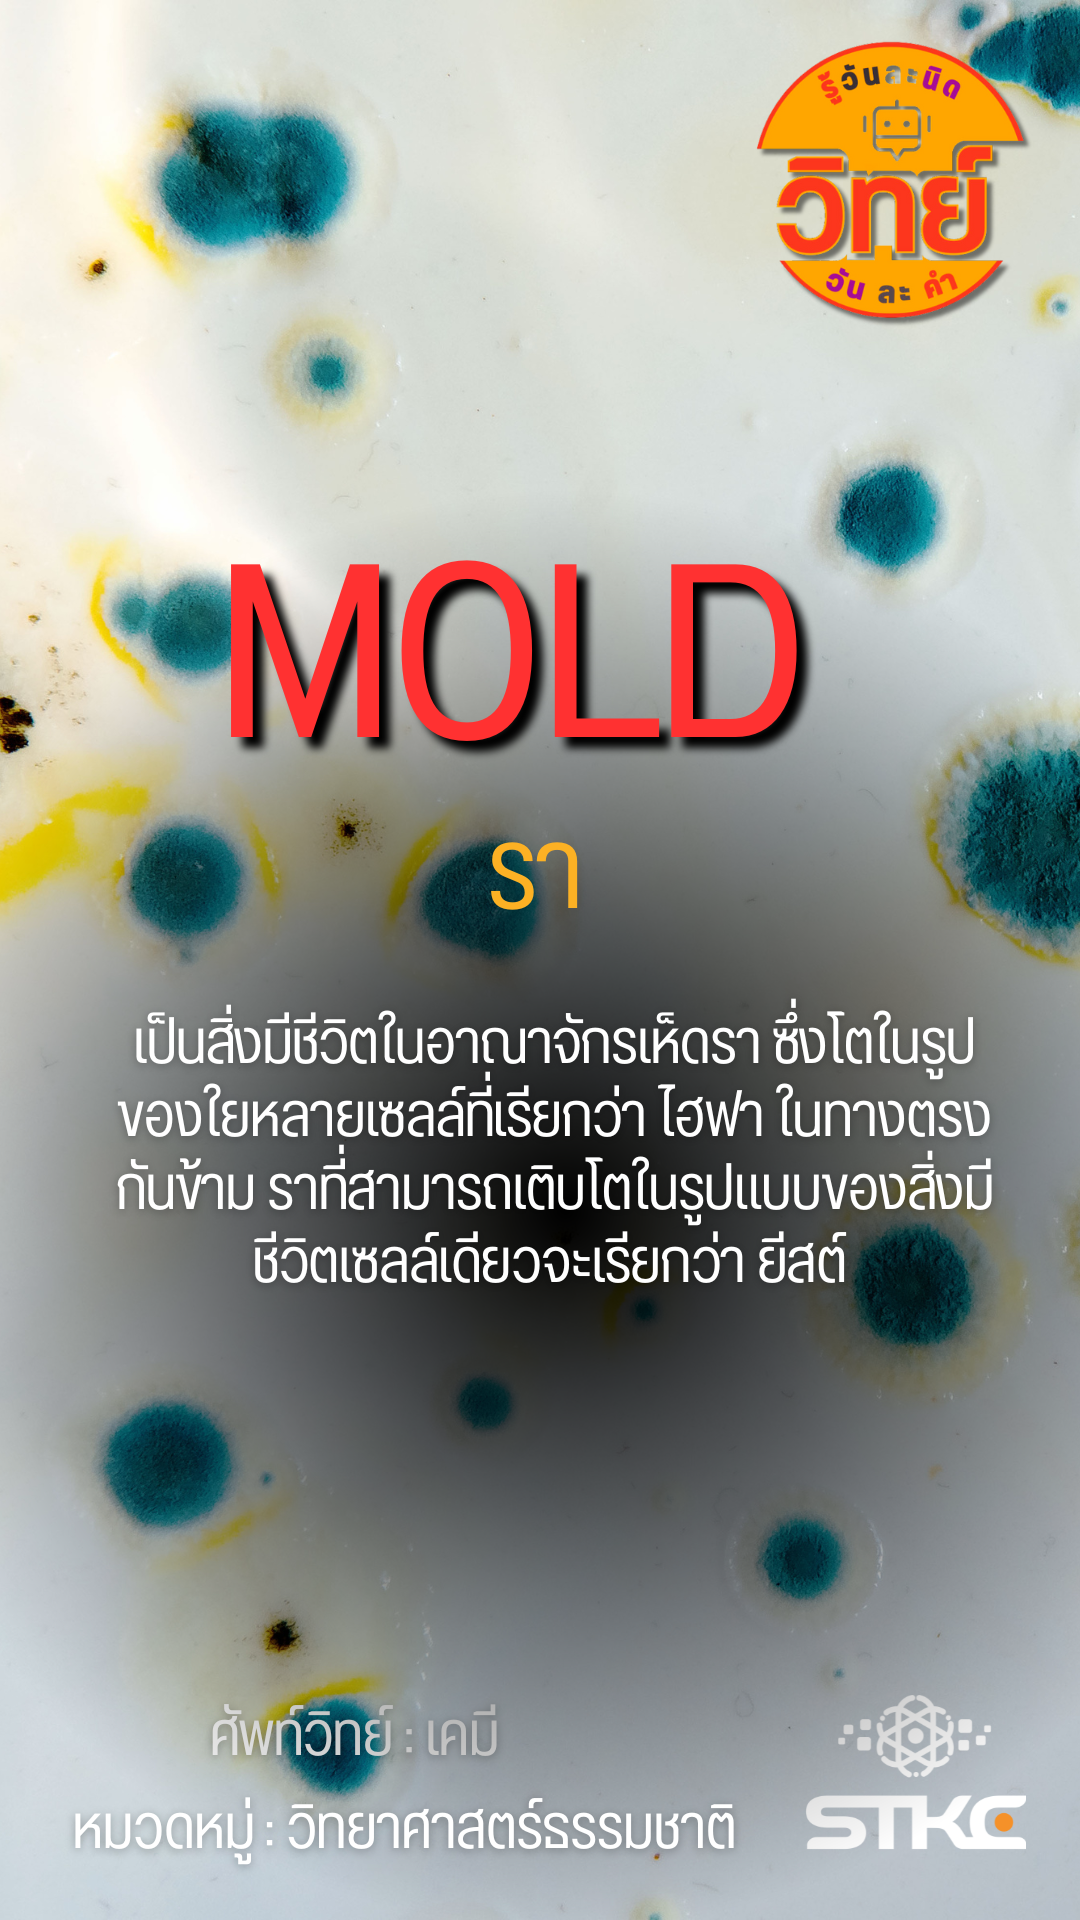

mold
Submitted by sasima.s on Mon, 2024-09-16 09:59
mold : รา
เป็นสิ่งมีชีวิตในอาณาจักรเห็ดรา ซึ่งโตในรูปของใยหลายเซลล์ที่เรียกว่า ไฮฟา ในทางตรงกันข้าม ราที่สามารถเติบโตในรูปแบบของสิ่งมีชีวิตเซลล์เดียวจะเรียกว่า ยีสต์
ภาพ:
หมวดหมู่ OECD:
- 1 read